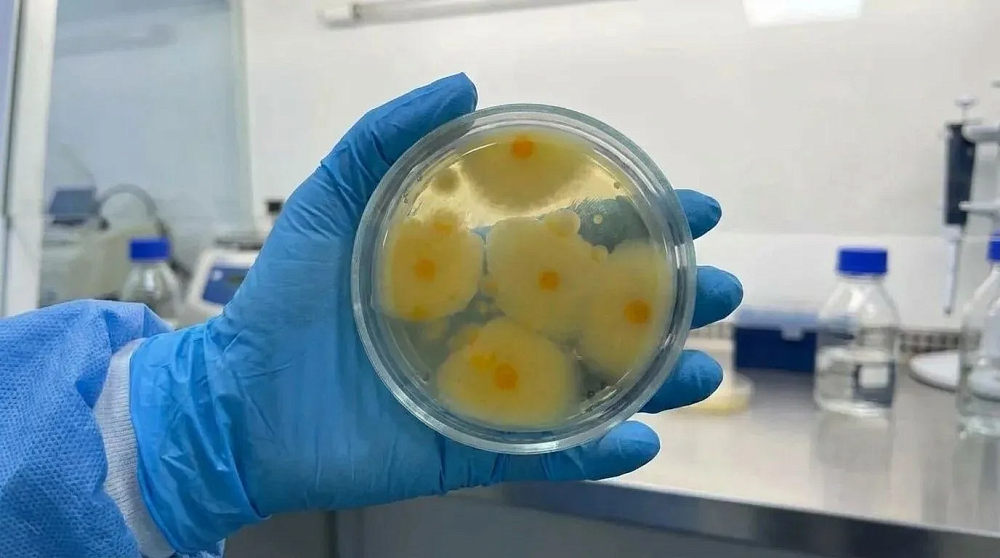
В астраханской селедке нашли 350-кратное превышение плесени

Превышение количества плесневых грибов в рыбных пресервах обнаружили специалисты Астраханского филиала ЦОК АПК.
Исследования проводились в ходе производственного контроля регионального предприятия-изготовителя рыбной продукции на соответствие ГОСТ для пищевых продуктов. Значения плесневых грибов в пробе пресервов из филе сельди в 350 раз превышали норматив.
«Повышенное значение количества плесени в пресервах может привести не только к порче продукта до конца срока годности, но и нанести вред организму человека из-за выработки токсичных веществ – микотоксинов, – уточняет заведующий испытательной лабораторией Астраханского филиала ФГБУ «ЦОК АПК» Аделя Шагалова. – Эти вещества могут накапливаться в организме и вызывать различные последствия: от острых отравлений до хронических нарушений. Именно поэтому важен строгий контроль пищевой продукции перед ее выпуском в оборот».
Информация о выявленных нарушениях направлена в территориальное управление Россельхознадзора по Ростовской, Волгоградской, Астраханской областям и Республике Калмыкия для принятия мер реагирования.
Фото: пресс-служба Астраханского филиала ЦОК АПК